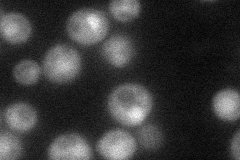
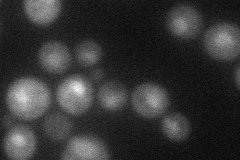
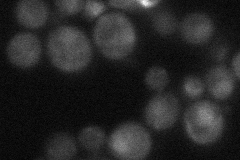

View description
Protein involved in 20S proteasome assembly; forms a heterodimer with Add66p that binds to proteasome precursors; similar to human PAC1 constituent of the PAC1-PAC2 complex involved in proteasome assembly
Localization:
Intensity:
Fold change:
Significance:
-
C’ GFP library in SD

cytosol21.15 -
N' NOP1pr-GFP in SD
cytosol,nucleus39.3454 -
N' TEF2pr-mCherry in SD
nucleus29.6005 -
N' NATIVEpr-GFP in SD
nucleus30.4441 -
N' TEF2pr-VC and Cyto-VN in SD

below threshold26.8681 -
C’ GFP library in SD+DTT

cytosol26.181.23No -
C’ GFP library in SD+H2O2

cytosol13.240.62No -
C’ GFP library in Starvation Media

cytosol21.811.03No -
C’ GFP library on the background of Pup2-DaMP

N/A -
C’ GFP library on the background of CCT mutant

N/A0N/AYes
